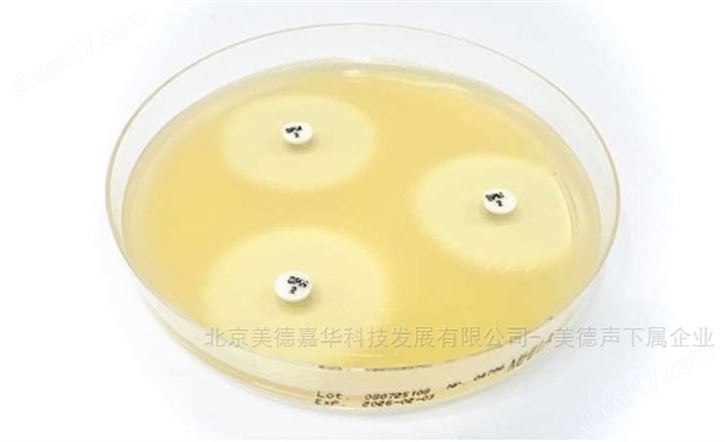
舒洛培南 Sulopenem藥敏紙片

關(guān)于美德聲超聲體模的詳細(xì)介紹
美德聲超聲體模由北京美德嘉華科技發(fā)展有限公司引入中國(guó)的醫(yī)療設(shè)備測(cè)試工具,專(zhuān)注于超聲設(shè)備的成像質(zhì)量評(píng)估,涵蓋幾何圖形、細(xì)節(jié)分辨率、對(duì)比度等關(guān)鍵參數(shù)測(cè)試,并提供多種型號(hào)以滿(mǎn)足不同測(cè)試需求。
美德聲超聲體模主要用于客觀評(píng)估超聲設(shè)備的成像質(zhì)量,涵蓋幾何圖形、細(xì)節(jié)分辨率、對(duì)比度等關(guān)鍵參數(shù)的測(cè)試。
產(chǎn)品特點(diǎn)
標(biāo)準(zhǔn)化測(cè)試:提供標(biāo)準(zhǔn)化、客觀的超聲設(shè)備性能檢測(cè)方案,支持長(zhǎng)期設(shè)備健康監(jiān)測(cè)。
多種型號(hào):美德聲超聲體模包含多種型號(hào),如111型低對(duì)比度幻象、616型膀胱掃描儀測(cè)試體積模型、2014型膀胱掃描儀幻影舊版本等,以滿(mǎn)足不同測(cè)試需求。
高精度與穩(wěn)定性:與實(shí)時(shí)模型相比,美德聲超聲體模隨著時(shí)間的推移而穩(wěn)定,為用戶(hù)提供了通過(guò)努力監(jiān)測(cè)設(shè)備的長(zhǎng)期健康狀況、復(fù)制虛擬圖像并與之前拍攝的圖像進(jìn)行比較的可能性。
易于使用:使用美德聲超聲體模進(jìn)行性能檢查需要很少的指導(dǎo),用戶(hù)可以在幾分鐘內(nèi)執(zhí)行測(cè)試,以確保獲得清晰的超聲圖像。
應(yīng)用場(chǎng)景
醫(yī)療設(shè)備質(zhì)量控制:美德聲超聲體模是醫(yī)學(xué)超聲成像領(lǐng)域中至關(guān)重要的質(zhì)量保證(QA)和質(zhì)量控制(QC)工具,用于測(cè)試、校準(zhǔn)、評(píng)估超聲設(shè)備的性能。
醫(yī)學(xué)教育與培訓(xùn):美德聲超聲體模能夠模擬人體的解剖結(jié)構(gòu)和病變特征,為學(xué)生提供直觀的視覺(jué)和操作體驗(yàn),幫助學(xué)生更好地理解超聲成像原理和操作技巧。同時(shí),它還可以用于標(biāo)準(zhǔn)化考核,以更客觀地評(píng)估學(xué)生的操作技能和診斷能力。
臨床研究:在超聲技術(shù)的臨床研究中,美德聲超聲體??梢杂糜隍?yàn)證新算法、新技術(shù)的有效性和準(zhǔn)確性。
相關(guān)產(chǎn)品
免責(zé)聲明
- 凡本網(wǎng)注明“來(lái)源:化工儀器網(wǎng)”的所有作品,均為浙江興旺寶明通網(wǎng)絡(luò)有限公司-化工儀器網(wǎng)合法擁有版權(quán)或有權(quán)使用的作品,未經(jīng)本網(wǎng)授權(quán)不得轉(zhuǎn)載、摘編或利用其它方式使用上述作品。已經(jīng)本網(wǎng)授權(quán)使用作品的,應(yīng)在授權(quán)范圍內(nèi)使用,并注明“來(lái)源:化工儀器網(wǎng)”。違反上述聲明者,本網(wǎng)將追究其相關(guān)法律責(zé)任。
- 本網(wǎng)轉(zhuǎn)載并注明自其他來(lái)源(非化工儀器網(wǎng))的作品,目的在于傳遞更多信息,并不代表本網(wǎng)贊同其觀點(diǎn)和對(duì)其真實(shí)性負(fù)責(zé),不承擔(dān)此類(lèi)作品侵權(quán)行為的直接責(zé)任及連帶責(zé)任。其他媒體、網(wǎng)站或個(gè)人從本網(wǎng)轉(zhuǎn)載時(shí),必須保留本網(wǎng)注明的作品第一來(lái)源,并自負(fù)版權(quán)等法律責(zé)任。
- 如涉及作品內(nèi)容、版權(quán)等問(wèn)題,請(qǐng)?jiān)谧髌钒l(fā)表之日起一周內(nèi)與本網(wǎng)聯(lián)系,否則視為放棄相關(guān)權(quán)利。
手機(jī)版
化工儀器網(wǎng)手機(jī)版
化工儀器網(wǎng)小程序
官方微信
公眾號(hào):chem17
掃碼關(guān)注視頻號(hào)

采購(gòu)中心